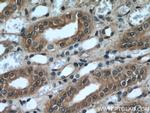
NR3C2 Antibody in Immunohistochemistry (Paraffin) (IHC (P))

Search
Proteintech
NR3C2 Polyclonal Antibody
{{$productOrderCtrl.translations['antibody.pdp.commerceCard.promotion.promotions']}}
{{$productOrderCtrl.translations['antibody.pdp.commerceCard.promotion.viewpromo']}}
{{$productOrderCtrl.translations['antibody.pdp.commerceCard.promotion.promocode']}}: {{promo.promoCode}} {{promo.promoTitle}} {{promo.promoDescription}}. {{$productOrderCtrl.translations['antibody.pdp.commerceCard.promotion.learnmore']}}
产品信息
21854-1-AP
种属反应
已发表种属
宿主/亚型
分类
类型
抗原
偶联物
形式
浓度
规格
纯化类型
保存液
内含物
保存条件
运输条件
产品详细信息
This antibody is a rabbit polyclonal antibody, specifically reacts with the 107 kDa MCR protein.
Immunogen sequence: METKGYHSL PEGLDMERRW GQVSQAVERS SLGPTERTDE NNYMEIVNVS CVSGAIPNNS TQGSSKEKQE LLPCLQQDNN RPGILTSDIK TELESKELSA TVAESMGLYM DSVRDADYSY EQQNQQGSMS PAKIYQNVEQ LVKFYKGNGH RPSTLSCVNT PLRSFMSDSG SSVNGGVMRA IVKSPIMCHE KSPSVCSPLN MTSSVCSPAG INSVSSTTAS FGSFPVHSPI TQGTPLTCSP NVENRGSRSH SPAHASNVGS PLSSPLSSMK SSISSPPSHC SVKSPVSSPN NVTLRSSVSS PANINNSRCS VSSPSNTNNR STLSSPAAST VGSICSPVNN AFSYTASGTS A (1-350 aa encoded by BC111758)
靶标信息
Steroid receptors are ligand-dependent, intracellular proteins that stimulate transcription of specific genes by binding to specific DNA sequences following activation by the appropriate hormone. Mineralocorticoids are a family of steroids, secreted by the adrenal cortex, necessary for the regulation of a number of metabolic processes including electrolyte regulation. These compounds exert their effect through their interaction with the mineralocorticoid receptor (MR) and that complex's subsequent association with DNA. Given the function of mineralocorticoids, it is not surprising to find that the kidney is a primary target organ for mineralocorticoids and that this organ has been shown to contain MR. The corresponding gene for the mineralocorticoid receptor is NR3C2.
仅用于科研。不用于诊断过程。未经明确授权不得转售。
生物信息学
蛋白别名: aldosterone receptor; Mineralocorticoid receptor; Mineralocorticoid receptor (aldosterone receptor); mineralocorticoid receptor 1; mineralocorticoid receptor 2; mineralocorticoid receptor delta; MR; Nuclear receptor subfamily 3 group C member 2; unnamed protein product
基因别名: MCR; MLR; MR; NR3C2; NR3C2VIT
UniProt ID: (Human) P08235, (Rat) P22199
Entrez Gene ID: (Human) 4306, (Mouse) 110784, (Rat) 25672